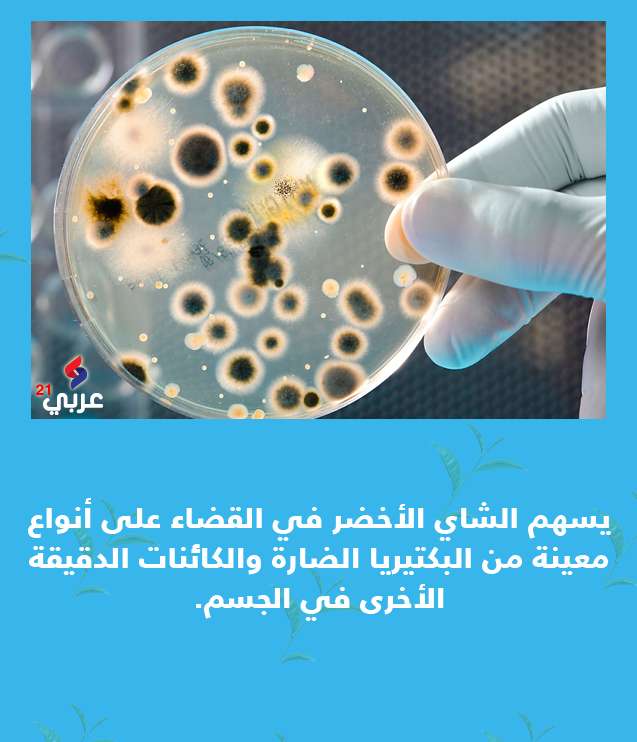

هذا الموقع يستخدم ملف تعريف الارتباط Cookie
8 فوائد تجعل الشاي الأخضر أفضل من القهوة (صور)

يتفوق الشاي الأخضر على القهوة كمنبه عام للجسم، ويتفوق عليها بمضادات الأكسدة التي يحتوي عليها، كما أنه يقي من بعض أنواع السرطان ومفيد للذاكرة.

المزيد حول هذا الموضوع
تناول أحماض "أوميغا 3" يقلص خطر الوفاة بأمراض القلب
29-Jun-16 09:12 AM
7 مشروبات رمضانية لا بد منها على مائدة الإفطار.. تعرف عليها
17-Jun-16 02:39 PM
إيطالي يتحدث بلغة جديدة بعد جراحة دماغية.. ما هي؟
17-Jun-16 09:06 AM

